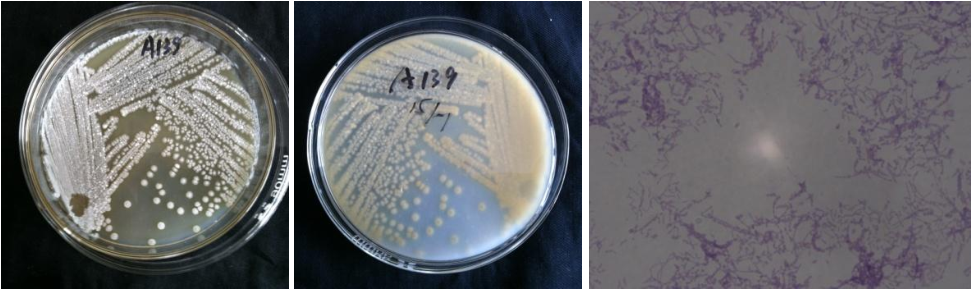

Loading...
| StrainNO | A139 |
| Classification | Amycolatopsis |
| 16s rDNA sequence | AAGGCTGACCGGTTTCGGGCGGGGATGAGTGGCGAACGGGTGAGTAACACGTGGGTAACCTGCCCTGTACTTTGGGATAAGCCCT GGAAACGGGGTCTAATACCGGATACGACTTGTCGAGGCATCTCGATGGGTGGAAAGTTTCAGCGGTACGGGATGGGCCCGCGGCC TATCAGCTTGTTGGTGGGGTGATGGCCTACCAAGGCGACGACGGGTAGCCGGCCTGAGAGGGTGTCCGGCCACACTGGGACTGAA ACACGGCCCAGACTCCTACGGGAGGCAGCAGTGGGGAATATTGCACAATGGGCGGAAGCCTGATGCAGCGACGCCGCGTGAGGGA TGACGGCCTTCGGGTTGTAAACCTCTTTCGCCAGGGACGAAGCGCGAGTGACGGTACCTGGAGAAGAAGCACCGGCTAACTACGT GCCAGCAGCCGCGGTAATACGTAGGGTGCAAGCGTTGTCCGGAATTATTGGGCGTAAAGAGCTCGTAGGCGGCTTGTCGCGTCTG CTGTGAAAATCCGGGGCTTAACTCCGGACCTGCAGTGGATACGGGCAGGCTTGAGTTCGGTAGGGGAGACTGGAATTCCTGGTGT AGCGGTGAAATGCGCAGATATCAGGAGGAACACCGGTGGCGAAGGCGGGTCTCTGGGCCGATACTGACGCTGAGGAGCGAAAGCG TGGGGAGCGAACAGGATTAGATACCCTGGTAGTCCACGCTGTAAACGTTGGGCGCTAGGTGTGGGCGACTTCCACGTTGTCCGTG CCGTAGCTAACGCATTAAGCGCCCCGCCTGGGGAGTACGGCCGCAAGGCTAAAACTCAAAGGAATTGACGGGGGCCCGCACAAGC GGCGGAGCATGTGGATTAATTCGATGCAACGCGAAGAACCTTACCTGGGCTTGACATGCACTGGAAACCGGCAGAGATGTCGGCC CCCTTGTGGCCGGTGTGCAGGTGGTGCATGGCTGTCGTCAGCTCGTGTCGTGAGATGTTGGGTTAAGTCCCGCAACGAGCGCAAC CCTTGTCCTGTGTTGCCAGCGCGTAATGGCGGGGACTCGCGGGAGACTGCCGGGGTCAACTCGGAGGAAGGTGGGGATGACGTCA AGTCATCATGCCCCTTATGTCCAGGGCTTCACACATGCTACAATGGCTGGTACAGAGGGCTGCGATACCGTGAGGTGGAGCGAAT CCCTTAAAGCCGGTCTCAGTTCGGATCGCAGTCTGCAACTCGACTGCGTGAAGTCGGAGTCGCTAGTAATCGCAGATCAGCAACG CTGCGGTGAATACGTTCCCGGGCCTTGTACACACCGCCCGTCACGTCATGAAAGTCGGTAACACCCGAAGCCCATGGCCCAACCC CTTGTGGGAGGGAGTGGTCGAAGGTGGGACTGGCGAC |
| Strain Morphology Photos | |
| Morphological Description |